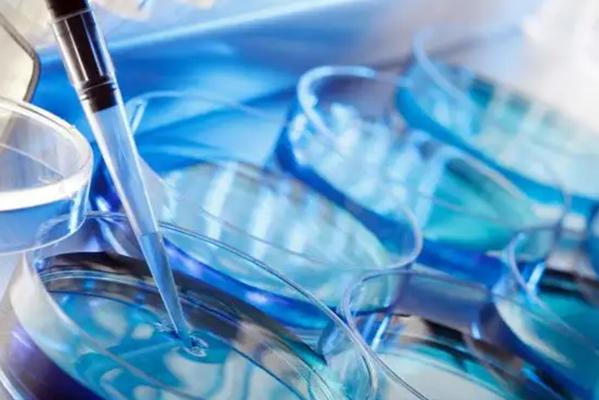
2022年临汾有医院可以做试管吗?临汾做试管婴儿多少钱?

更新时间:2023-10-26
2022年临汾有医院可以做试管吗?临汾做试管婴儿多少钱?临汾能做试管婴儿的医院很少,只有一家,临汾市试管医院就是临汾,仅有能做试管婴儿的公试管医院,因此,很多临汾很多本地的不孕家庭,都能在本地进行试管婴儿助孕,圆生子梦。那么接下来为大家介绍一下临汾的试管医院。

不用问临汾哪家医院可以做试管婴儿。市试管医院首例试管婴儿的诞生标准是临汾市历史上不能做试管婴儿的空白被填补。让我们先了解一下大家在临汾试管婴儿花了多少钱吧:
我今年在临汾市试管医院做的,没有成功,花了3万左右。我排卵不好,用进口药。如果用国产药,可以少花三分之一。丽粒
目前试管的整体成功率约为40%,但相对个人来说,这取决于运气。有的100%成功,有的300次不成功。至于钱,这取决于你在哪里,当地的医疗费用和消费水平。一般来说,如果一切顺利,会有3000-50000,有些地方会有20000多。迟山
临汾市试管医院的费用,前期夫妻双方检查3000左右,降调促排1.5万左右,取卵8000,移植3000。如果是第二代试管,总费用在3万左右。比较宝贝你
在国内外做试管婴儿,做第几代试管的价格还是有区别的。现在国内首位代和第二代试管的技术还是很成熟的,但是国内可以做第三代试管的医院比较少,常规试管婴儿的费用一般在3-5万元左右。
放心笑
有人说,我国做试管婴儿的三甲医院,其实医疗技术都差不多,成功率也差不多。比较重要的是根据试管夫妇自己的情况来决定。我也觉得还是在临汾附近做。毕竟距离近,跑来跑去更方便。山高云阔
事实上,只要他们有这个水平和技术标准,无论他们的声誉是否大小,成功率比较重要的是看看他们自己的身体状况和心态,另一点是良好的怀孕。卿弦季鸢
1、生殖免疫检查:主要有抗自己体内膜抗体、抗心磷脂抗体、抗精子抗体、抗透明带抗体、抗卵巢抗体、抗绒毛抗体、抗滋养层抗体等;
2、染色体检查:通过使用外周血来检测民主或流产物中是否存在染色体异常;
3、宫腔镜:看女性是否有炎性肿瘤、异物、畸形、粘连、血管瘤等影响试管成功的疾病。

2022年临汾有医院可以做试管吗?临汾做试管婴儿多少钱?以上便是2022年临汾有医院可以做试管吗?临汾做试管婴儿多少钱?的全部内容,想了解更多试管医院费用等问题,可以咨询专业的助孕医师!
以上就是医院招聘网小编为大家整理的《2022年临汾有医院可以做试管吗?临汾做试管婴儿多少钱?》相关信息,希望大家喜欢。
内容版权声明:本网站部分内容由网上整理转发,如有侵权请联系管理员进行删除.